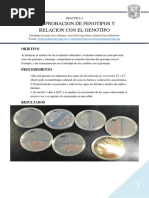

0% encontró este documento útil (0 votos)
4K vistas3 páginasPrueba Manitol
Este documento describe tres pruebas bioquímicas (manitol, movilidad y nitratos) que se pueden realizar cultivando microorganismos en un medio llamado Manitol Movilidad. La prueba de manitol detecta si los gérmenes fermentan manitol, la prueba de movilidad determina si son móviles o inmóviles, y la prueba de nitratos mide su capacidad para reducir nitratos a nitritos. El documento explica los principios de cada prueba y algunos ejemplos de cómo se pued
Cargado por
Dunkellicht PoeDerechos de autor
© Attribution Non-Commercial (BY-NC)
Nos tomamos en serio los derechos de los contenidos. Si sospechas que se trata de tu contenido, reclámalo aquí.
Formatos disponibles
Descarga como PDF, TXT o lee en línea desde Scribd
0% encontró este documento útil (0 votos)
4K vistas3 páginasPrueba Manitol
Este documento describe tres pruebas bioquímicas (manitol, movilidad y nitratos) que se pueden realizar cultivando microorganismos en un medio llamado Manitol Movilidad. La prueba de manitol detecta si los gérmenes fermentan manitol, la prueba de movilidad determina si son móviles o inmóviles, y la prueba de nitratos mide su capacidad para reducir nitratos a nitritos. El documento explica los principios de cada prueba y algunos ejemplos de cómo se pued
Cargado por
Dunkellicht PoeDerechos de autor
© Attribution Non-Commercial (BY-NC)
Nos tomamos en serio los derechos de los contenidos. Si sospechas que se trata de tu contenido, reclámalo aquí.
Formatos disponibles
Descarga como PDF, TXT o lee en línea desde Scribd